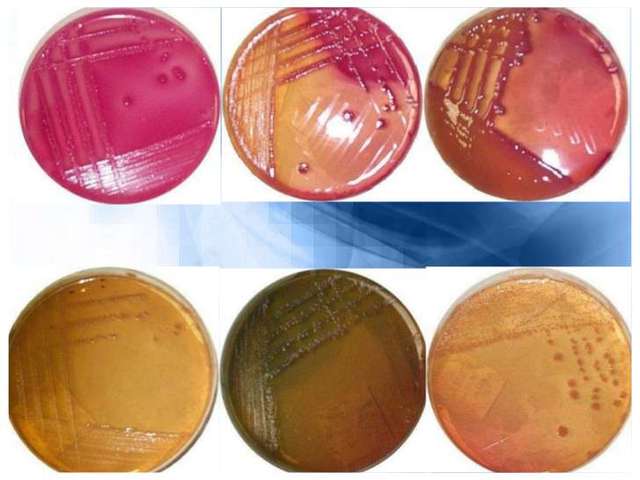
Robert Koch,Crecimiento de bacterias en medios sólidos

-
Girolamo Frascatoro estudia enfermedades contagiosas y propone una teoría sobre su origen
-
Los primeros microscopios compuestos producidos por los Janssen eran simplemente un tubo de 70 cm de largo y 9 cm de diámetro con una lente convexa en cada extremo. Este instrumento llegó a tener entre 3 y 9 aumentos, dependiendo del tamaño de la abertura del diafragma.
-
La microbiologia se conoce como "la ciencia encargada del estudio de los microorganismos, seres vivos pequeños,rama de la biología dedicada a estudiar los organismos que son solo visibles a través del microscopio pero que para poder desarrollarse como una ciencia tuvo que atravesar las dificultades que exponen el conservatismo y el respaldo a las ideas clásicas, es por estas razones que la microbiologia tal vez se conoce solo de unos siglos atrás.
-
Observo por primera vez embriones animales y vegetales,observables en las bandas parenquimatosas que se insinúan transversalmente entre los vasos y las fibras del tallo de las plantas.
-
consiguió perfeccionar la técnica del pulido de lentes y, combinando diferentes lentes en cuadriláteros de oro, plata o cobre, logró construir microscopios de mayor aumento,encontró organismos vivos a los que llamó "animálculos": así se abría ante sus ojos y los de los demás observadores un mundo microscópico.
-
El primero en refutar la teoría de la generación espontanea de gusanos.
-
(Antony Leeuwenhoek) Fue el primero en realizar importantes observaciones con microscopios fabricados por él mismo. Correspondiente de la Royal Society de Londres, a la que se afilió en 1680. Desde 1674 hasta su muerte realizó numerosos descubrimientos. Introdujo mejoras en la fabricación de microscopios y fue el precursor de la biología experimental, la biología celular y la microbiología
-
observo bacterias y otros microorganismos,describe lo que actualmente denominamos protozoarios, especialmente los ciliados de los que se alimentan de las algas
-
Leeuwenhoek fue consciente de que sus observaciones, que mostraban que en la semilla contenida en los testículos estaba el principio de la reproducción de los mamíferos, iba a chocar con el paradigma de su época, porque sus observaciones estaban en contra de las tesis desarrolladas por grandes sabios de la época
-
Afirmo que los microorganismos pueden aparecer de forma espontanea a partir de un caldo nutritivo hervido
-
registró los casos de viruela humana y animal e intuyó que la viruela del ganado podía dar inmunidad frente a la viruela humana clásica.Estas gotas fueron sembradas en el brazo de un niño y con ello se obtuvo, además de la cicatriz, la inmunidad.
-
realiza experimentos relacionados con la fermentacion y putrefaccion por microorganismos,Los microorganismos descomponedores, a su vez, se pueden subdividir en dos grupos: los que llevan a cabo una descomposición oxidante y los que generan una descomposición fermentativa
-
Realizo el primer estudio epideologico de colera en Londres
-
el lavado de manos para detener la propagación de las enfermedades infecciosas de las heridas, de las
fiebres purulentas, y las epidemias de erisipela y tétanos -
encontró al inspeccionar el esperma de salmón y el pus de heridas abiertas.Ya que la encontró solamente en los núcleos lo llamó Nucleína.Después recibió el nombre de ácido nucleído y por último se le denomino Ácido Desoxirribonucleico
-
Descubre que el carbunco o ántrax es causado por Baciltus anthracis,descubre el Mycobacterium tuberculosis
-
incubó huevecillos de mosquito y dejó que los mosquitos se alimentaran de pacientes infectados con la fiebre amarilla. Posteriormente se permitió que los mosquitos se alimentaran de dos voluntarios, los cuales se enfermaron después de que los picaran los mosquitos.
-
el papel del mosquito Aedes gracias al cual se pudo descubrir una vacuna para la prevención. En 1901, la enfermedad fue erradicada en La Habana y el Caribe,Se cree que la fiebre amarilla ha sido la causante de devastaciones en el pasado y que fue, transmitida, probablemente, de primates a humanos. El foco infeccioso se concentraba en las zonas de alta densidad de población.
-
Sembró en gelatina una mezcla de bacterias, después de fundir el medio por calentamiento, y vertió en este medio inoculado en una placa de cristal esterilizada y fría, para endurecerlo. Allí donde las bacterias quedaban atrapadas al irse solidificando el medio, se multiplicaban formando una masa, llamada colonia, visible a simple vista, dichas colonias debían ser puras, es decir contener un solo tipo de bacteria.
-
La tinción de Gram o coloración de Gram es un tipo de tinción diferencial empleado en bacteriología para la visualización de bacterias, sobre todo en muestras clínicas
-
vacuna obtenida de tejido nervioso (médula espinal de conejo desecada al aire), abrió el paso a muy importantes investigaciones frente a esta enfermedad y sobre todo inició el concepto de inmunoterapia con vacuna
-
el bacteriólogo danés Christian Gram. El proceso tradicional fue mejorado por Hucker en 1921, hallando la manera de que los reactivos fueran más estables y mejorando la calidad diferenciadora del proceso.
-
Descubre la escherichiacoli,organismo procariota más estudiado por el ser humano. Se trata de una enterobacteria que se encuentra generalmente en los intestinos animales, y por ende en las aguas negras, pero se lo puede encontrar en todos lados, dado que es un organismo ubicuo
-
título Manual práctico de cirugía antiséptica,la importancia de los agentes microbianos en la infección operatoria,La adopción de medidas asépticas permitió a los cirujanos acceder a zonas que hasta entonces habían estado muy limitadas debido a las infecciones.
-
La placa de Petri es un recipiente redondo, de cristal o plástico, con una cubierta de la misma forma que la placa, pero algo más grande de diámetro, para que se pueda colocar encima y cerrar el recipiente
-
Demostró que la fiebre de las Montañas Rocosas es transmitida por garrapatas.un microbio que presenta algunas diferencias respecto de las bacterias y los virus. Rickettsia rickettsii es una bacteria intracelular que se transmite a los seres humanos por las garrapatas
-
Ehrlich inyectó a conejos afectados de sífilis varias dosis de un producto químico de base arsénica que había inventado. Tras repetidos intentos, los conejos se recuperaban. Un par de semanas más tarde, Ehrlich repitió el experimento con más conejos infectados. Al cabo de tres semanas, también quedaron libres de síntomas. Ehrlich no sólo había descubierto la primera cura efectiva para la sífilis
-
Demuestra que la fiebre de las Montañas Rocosas es transmitida por garrapatas, y aisló el microorganismo causante de la enfermedad
-
La insulina interviene en el aprovechamiento metabólico de los nutrientes, sobre todo con el anabolismo de los glúcidos
-
estudiando cultivos bacterianos de Staphylococcus aureus en el sótano del laboratorio del Hospital St. Mary en Londres, filtrado libre de células que inyectó a conejos, comprobando así que carecía de toxicidad. También apreció su utilidad para aislar Haemophilus influenzae a partir de esputos.
-
se involucró en desarrollar el primer microscopio electrónico producido comercialmente en 1939. Al igual que desarrollando la tecnología del microscopio electrónico,utiliza electrones en lugar de fotones o luz visible para formar imágenes de objetos diminutos. Los microscopios electrónicos permiten alcanzar ampliaciones antes que los mejores microscopios ópticos, debido a que la longitud de onda de los electrones es mucho menor que la de los fotones visibles.
-
secuencia el genoma del Saccharopolyspora erythraea, el microorganismo productor del antibiótico eritromicina,El compuesto se halló en los productos metabólicos de una cepa
-
respecto de sus funcionalidades de transmisión de la información genética. Por aquella época no se conocían los mecanismos de replicación del ADN y como estaba este ácido implicado en la generación de las proteínas.
-
propuso el primer mecanismo para explicar cómo pudo haber ocurrido esta asociación. Margulis postuló la llamada "teoría endosimbiótica" para explicar el origen de algunas organelas eucariontes.
-
La prueba utiliza cepas de Salmonella typhimurium, construidas por ingeniería
genética, capaces de detectar compuestos que causan mutaciones génicas por
dislocamiento del cuadro de lectura (frameshift) o por sustitución de pares de
bases del ADN -
esta técnica para secuenciar el genoma del bacteriófago Phi-X174, el primer ácido nucleico secuenciado totalmente en la historia. Realizó este trabajo manualmente, sin ayuda de ningún automatismo. Este trabajo fue base fundamental para proyectos tan ambiciosos como el Proyecto Genoma Humano
-
La Organización Mundial de la Salud declara la erradicación de la viruela,fue una enfermedad infecciosa grave, contagiosa, causada por el Variola virus, que en algunos casos podía provocar la muerte. No hubo nunca tratamiento especial para la viruela y las únicas formas de prevención eran la inoculación o la vacunación
-
Conjunto de enfermedades de muy diverso tipo generalmente, procesos infecciosos o tumorales que resultan de la infección por el virus de la inmunodeficiencia humana,En materia de la enfermedad, y expresó que debe haber un cambio de paradigma la manera de diagnosticar y tratar la patología,
-
Descubren la mayor celula procariota Epulopiscium fishelsoni
-
síndrome respiratorio agudo, SARS), enfermedad respiratoria producida por un coronavirus,Mycoplasma pneumoniae, Coxiella Burnetti, Legionela Pneumophila, Chlamydophila pneumoniae y Chlamydophila psitacci.
-
La pandemia de gripe A (H1N1), ha sido causada por una variante del Influenzavirus A de origen porcino (subtipo H1N1)
-
La enfermedad por el virus del Ebola (EVE), antes llamada fiebre hemorrágica del Ebola, es un enfermedad grave, a menudo mortal en el ser humano
-
El virus zika es causado por la picadura de un mosquito y se cataloga como un arbovirus perteneciente al género flavivirus, que son aquellos que animales invertebrados como zancudos y garrapatas le transmiten al ser humano.
-
La fiebre chikungunya es una enfermedad vírica transmitida al ser humano por mosquitos infectados. Además de fiebre y fuertes dolores articulares, produce otros síntomas, tales como dolores musculares, dolores de cabeza, náuseas, cansancio y erupciones cutáneas
-
Con un microscopio que él mismo fabricó, notó que el corcho y otros tejidos vegetales están constituidos por pequeñas cavidades separadas por paredes. Llamó a estas cavidades "células", que significa "habitaciones pequeñas
Want to make a timeline like this?
Use Timetoast to turn dates, events, milestones, and phases into a clear visual timeline you can build and share. Timetoast is a timeline maker for work, school, research, and stories.